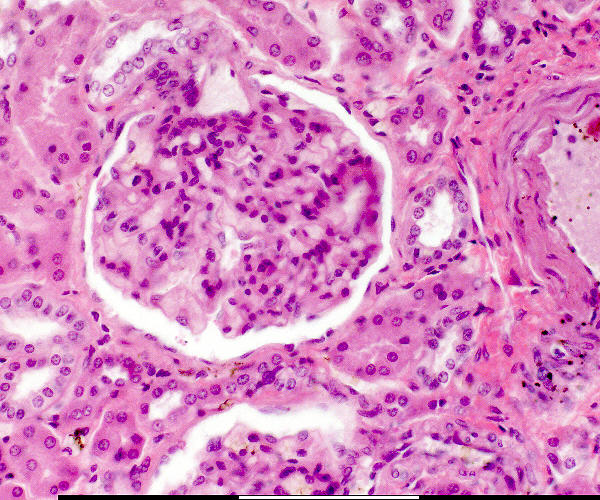

![]()
![]() Bloedvat / Blood vessel
Bloedvat / Blood vessel
![]()
![]() Versamelbuis / Collecting tubule
Versamelbuis / Collecting tubule
![]()
![]() Makula densa / Macula densa
Makula densa / Macula densa
![]()
![]() Pariëtale selle / Parietal cells
Pariëtale selle / Parietal cells
![]()
![]() Pariëtale laag / Parietal layer
Pariëtale laag / Parietal layer
![]()
![]() Podosiete / Podocytes
Podosiete / Podocytes
![]()
![]() Urinêre spasie / Urinary space
Urinêre spasie / Urinary space
![]()
![]() Vaskulêre pool / Vascular pole
Vaskulêre pool / Vascular pole
![]()
![]() Visserale laag / Visceral layer
Visserale laag / Visceral layer
![]()
![]() Jukstaglomerulêre apparaat / Juxtaglomerular apparatus
Jukstaglomerulêre apparaat / Juxtaglomerular apparatus